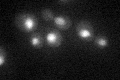
YBL046W
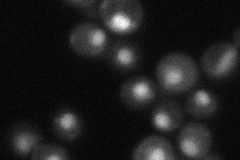
YBL046W

View description
Putative regulatory subunit of an evolutionarily conserved protein phosphatase; localization is cell-cycle dependent and regulated by Cdc28p phosphorylation; required for cisplatin resistance; homolog of mammalian R2
Localization:
Intensity:
Fold change:
Significance:
-
C’ GFP library in SD
nucleus35.11 -
N' NOP1pr-GFP in SD

nucleus57.4295 -
N' TEF2pr-mCherry in SD

nucleus59.6096 -
N' NATIVEpr-GFP in SD
nucleus39.2402 -
N' TEF2pr-VC and Cyto-VN in SD

nucleus34.9987 -
C’ GFP library in SD+DTT

nucleus34.660.98No -
C’ GFP library in SD+H2O2

nucleus36.871.05No -
C’ GFP library in Starvation Media

nucleus23.780.67Yes -
C’ GFP library on the background of Pup2-DaMP

nucleus -
C’ GFP library on the background of CCT mutant

nucleus36.36811.03564No
